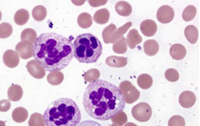

Magazin
#75 MEDIZINISCHES VERSORGUNGSZENTRUM LABOR 28 JUNI 2024

Liebe Kolleginnen und Kollegen,
wir freuen uns, Ihnen die Juni-Ausgabe des Labor 28-Magazins vorstellen zu dürfen. In dieser Ausgabe lesen Sie Beiträge unserer Fachärztinnen und Fachärzte im Labor zu diesen Themen:
- Patientenzentriert und qualitätsorientiert – so sollte Gesundheitspolitik ausgerichtet sein
- Fallvorstellung: Meningeosis carcinomatosa bei einer 76-jährigen Patientin
- Empfehlung zur Standardimpfung von Säuglingen und Kleinkindern gegen Meningokokken der Serogruppe B
- Richtlinie Hämotherapie: Was ändert sich mit der Gesamtnovelle 2023?
- Neue ACR/EULAR-Klassifikationskriterien für das Antiphospholipid-Syndrom (APS)
- Kryptosporidien: Nicht nur bei Immunsuppression relevant
- Fallvorstellung: Blutbildveränderungen beim Vitamin B12-Mangel
Patientenzentriert und qualitätsorientiert – so sollte Gesundheitspolitik ausgerichtet sein
DR. MED. MICHAEL MÜLLER
 Egal, wohin man schaut: An allen Ecken und Kanten gibt es eine teils erhebliche Unzufriedenheit mit der aktuellen Ausrichtung der Gesundheitspolitik und den seitens des Bundesministers für Gesundheit, Herrn Prof. Dr. Karl Lauterbach, vorgestellten Regelungsentwürfen. Die Versorgung der Bevölkerung mit fachärztlicher Labordiagnostik ist dabei gleich in beiden aktuellen Vorhaben direkt oder indirekt betroffen: Krankenhausversorgungsverbesserungsgesetz (KHVVG) und Gesunheitsversorgungsstärkungsgesetz (GVSG). Gleichzeitig hat der Bewertungsausschuss Mitte April einen Beschluss zu einer Laborreform gefasst, die zum 1. Januar 2025 greifen soll und insgesamt sehr kritisch zu sehen ist. Artikel lesen...
Egal, wohin man schaut: An allen Ecken und Kanten gibt es eine teils erhebliche Unzufriedenheit mit der aktuellen Ausrichtung der Gesundheitspolitik und den seitens des Bundesministers für Gesundheit, Herrn Prof. Dr. Karl Lauterbach, vorgestellten Regelungsentwürfen. Die Versorgung der Bevölkerung mit fachärztlicher Labordiagnostik ist dabei gleich in beiden aktuellen Vorhaben direkt oder indirekt betroffen: Krankenhausversorgungsverbesserungsgesetz (KHVVG) und Gesunheitsversorgungsstärkungsgesetz (GVSG). Gleichzeitig hat der Bewertungsausschuss Mitte April einen Beschluss zu einer Laborreform gefasst, die zum 1. Januar 2025 greifen soll und insgesamt sehr kritisch zu sehen ist. Artikel lesen...
Fallvorstellung: Meningeosis carcinomatosa bei einer 76-jährigen Patientin
DR. MED. JUSTIN ROTHSCHUH
 Im Januar dieses Jahres erreichte uns ein Auftrag aus einer neurologischen Fachklinik bezüglich einer 76-jährigen Patientin mit einer seit November 2023 progredienten Radikulitis. Aktuell zeigte sich nun zusätzlich eine Paraplegie.
Im Januar dieses Jahres erreichte uns ein Auftrag aus einer neurologischen Fachklinik bezüglich einer 76-jährigen Patientin mit einer seit November 2023 progredienten Radikulitis. Aktuell zeigte sich nun zusätzlich eine Paraplegie.
Empfehlung zur Standardimpfung von Säuglingen und Kleinkindern gegen Meningokokken der Serogruppe B
DR. MED. THOMAS FREUND
 Anfang des Jahres 2024 erweiterte die Ständige Impfkommission (STIKO) des Robert Koch-Instituts (RKI) die bestehende MenB-Indikationsimpfung um eine Empfehlung zur MenB-Standardimpfung für Säuglinge und Kleinkinder im Alter von unter fünf Jahren. Artikel lesen...
Anfang des Jahres 2024 erweiterte die Ständige Impfkommission (STIKO) des Robert Koch-Instituts (RKI) die bestehende MenB-Indikationsimpfung um eine Empfehlung zur MenB-Standardimpfung für Säuglinge und Kleinkinder im Alter von unter fünf Jahren. Artikel lesen...
Richtlinie Hämotherapie: Was ändert sich mit der Gesamtnovelle 2023?
DR. MED. LUKAS WAGNER | FRITHJOF HERRLINGER
 Die „Richtlinie zur Gewinnung von Blut und Blutbestandteilen und zur Anwendung von Blutprodukten“ (Richtlinie Hämotherapie) wurde von der Bundesärztekammer in Zusammenarbeit mit dem Paul-Ehrlich-Institut (PEI) novelliert. Die Veröffentlichung der Gesamtnovelle 2023 im Deutschen Ärzteblatt erfolgte im September 2023. Die vorherige Gesamtnovelle stammte aus dem Jahre 2017 und wurde in den Jahren 2019 und 2021 geringfügig angepasst. Artikel lesen...
Die „Richtlinie zur Gewinnung von Blut und Blutbestandteilen und zur Anwendung von Blutprodukten“ (Richtlinie Hämotherapie) wurde von der Bundesärztekammer in Zusammenarbeit mit dem Paul-Ehrlich-Institut (PEI) novelliert. Die Veröffentlichung der Gesamtnovelle 2023 im Deutschen Ärzteblatt erfolgte im September 2023. Die vorherige Gesamtnovelle stammte aus dem Jahre 2017 und wurde in den Jahren 2019 und 2021 geringfügig angepasst. Artikel lesen...
Neue ACR/EULAR-Klassifikationskriterien für das Antiphospholipid-Syndrom (APS)
DR. MED. ATHANASIOS VERGOPOULOS
 Das Antiphospholipid-Syndrom (APS) ist eine systemische Autoimmunerkrankung, die durch das Auftreten von venösen und arteriellen Thrombosen (insbesondere tiefe Bein- und Becken- oder Armvenenthrombosen, Lungenembolien, Schlaganfall) und/oder Schwangerschaftskomplikationen (Frühaborte und -geburten) charakterisiert ist. Artikel lesen...
Das Antiphospholipid-Syndrom (APS) ist eine systemische Autoimmunerkrankung, die durch das Auftreten von venösen und arteriellen Thrombosen (insbesondere tiefe Bein- und Becken- oder Armvenenthrombosen, Lungenembolien, Schlaganfall) und/oder Schwangerschaftskomplikationen (Frühaborte und -geburten) charakterisiert ist. Artikel lesen...
Kryptosporidien: Nicht nur bei Immunsuppression relevant
PROF. DR. MED. RALF IGNATIUS
 Kryptosporidien sind weltweit verbreitet. Bekannt sind mittlerweile mindestens vierundvierzig Spezies, die größtenteils auch Haus- und Wildtiere infizieren können; Cryptosporidium hominis wird jedoch fast ausschließlich beim Menschen gefunden. Neben C. hominis wird vor allem C. parvum beim Menschen nachgewiesen. Artikel lesen...
Kryptosporidien sind weltweit verbreitet. Bekannt sind mittlerweile mindestens vierundvierzig Spezies, die größtenteils auch Haus- und Wildtiere infizieren können; Cryptosporidium hominis wird jedoch fast ausschließlich beim Menschen gefunden. Neben C. hominis wird vor allem C. parvum beim Menschen nachgewiesen. Artikel lesen...
Fallvorstellung: Blutbildveränderungen beim Vitamin B12-Mangel
DR. MED. ADRIANNA JAGIELLO
Eine 68-jährige Patientin stellte sich bei zunehmender Abgeschlagenheit und gehäuften Infekten in der Arztpraxis vor. Artikel lesen...
Eine 68-jährige Patientin stellte sich bei zunehmender Abgeschlagenheit und gehäuften Infekten in der Arztpraxis vor. Artikel lesen...
